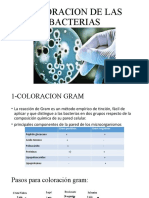

0% encontró este documento útil (0 votos)
284 vistas13 páginasPractico5 Tupiza
Este documento describe el diseño de primers para la clonación del gen LacZ del plásmido pTZ18U en el plásmido pFL260 utilizando el programa Serial Cloner. Se diseñaron los primers forward "attgccatgg atgaccatgattacgaa" y reverse "ttaacggccg ctaatcaagttttttgg" y se analizó su información termodinámica. El mapa de restricción muestra la inserción exitosa del fragmento entre los sitios de restricción de las enzimas Ncol y Eagl.
Cargado por
Beto Vnoo Az SzDerechos de autor
© © All Rights Reserved
Nos tomamos en serio los derechos de los contenidos. Si sospechas que se trata de tu contenido, reclámalo aquí.
Formatos disponibles
Descarga como DOCX, PDF, TXT o lee en línea desde Scribd
0% encontró este documento útil (0 votos)
284 vistas13 páginasPractico5 Tupiza
Este documento describe el diseño de primers para la clonación del gen LacZ del plásmido pTZ18U en el plásmido pFL260 utilizando el programa Serial Cloner. Se diseñaron los primers forward "attgccatgg atgaccatgattacgaa" y reverse "ttaacggccg ctaatcaagttttttgg" y se analizó su información termodinámica. El mapa de restricción muestra la inserción exitosa del fragmento entre los sitios de restricción de las enzimas Ncol y Eagl.
Cargado por
Beto Vnoo Az SzDerechos de autor
© © All Rights Reserved
Nos tomamos en serio los derechos de los contenidos. Si sospechas que se trata de tu contenido, reclámalo aquí.
Formatos disponibles
Descarga como DOCX, PDF, TXT o lee en línea desde Scribd